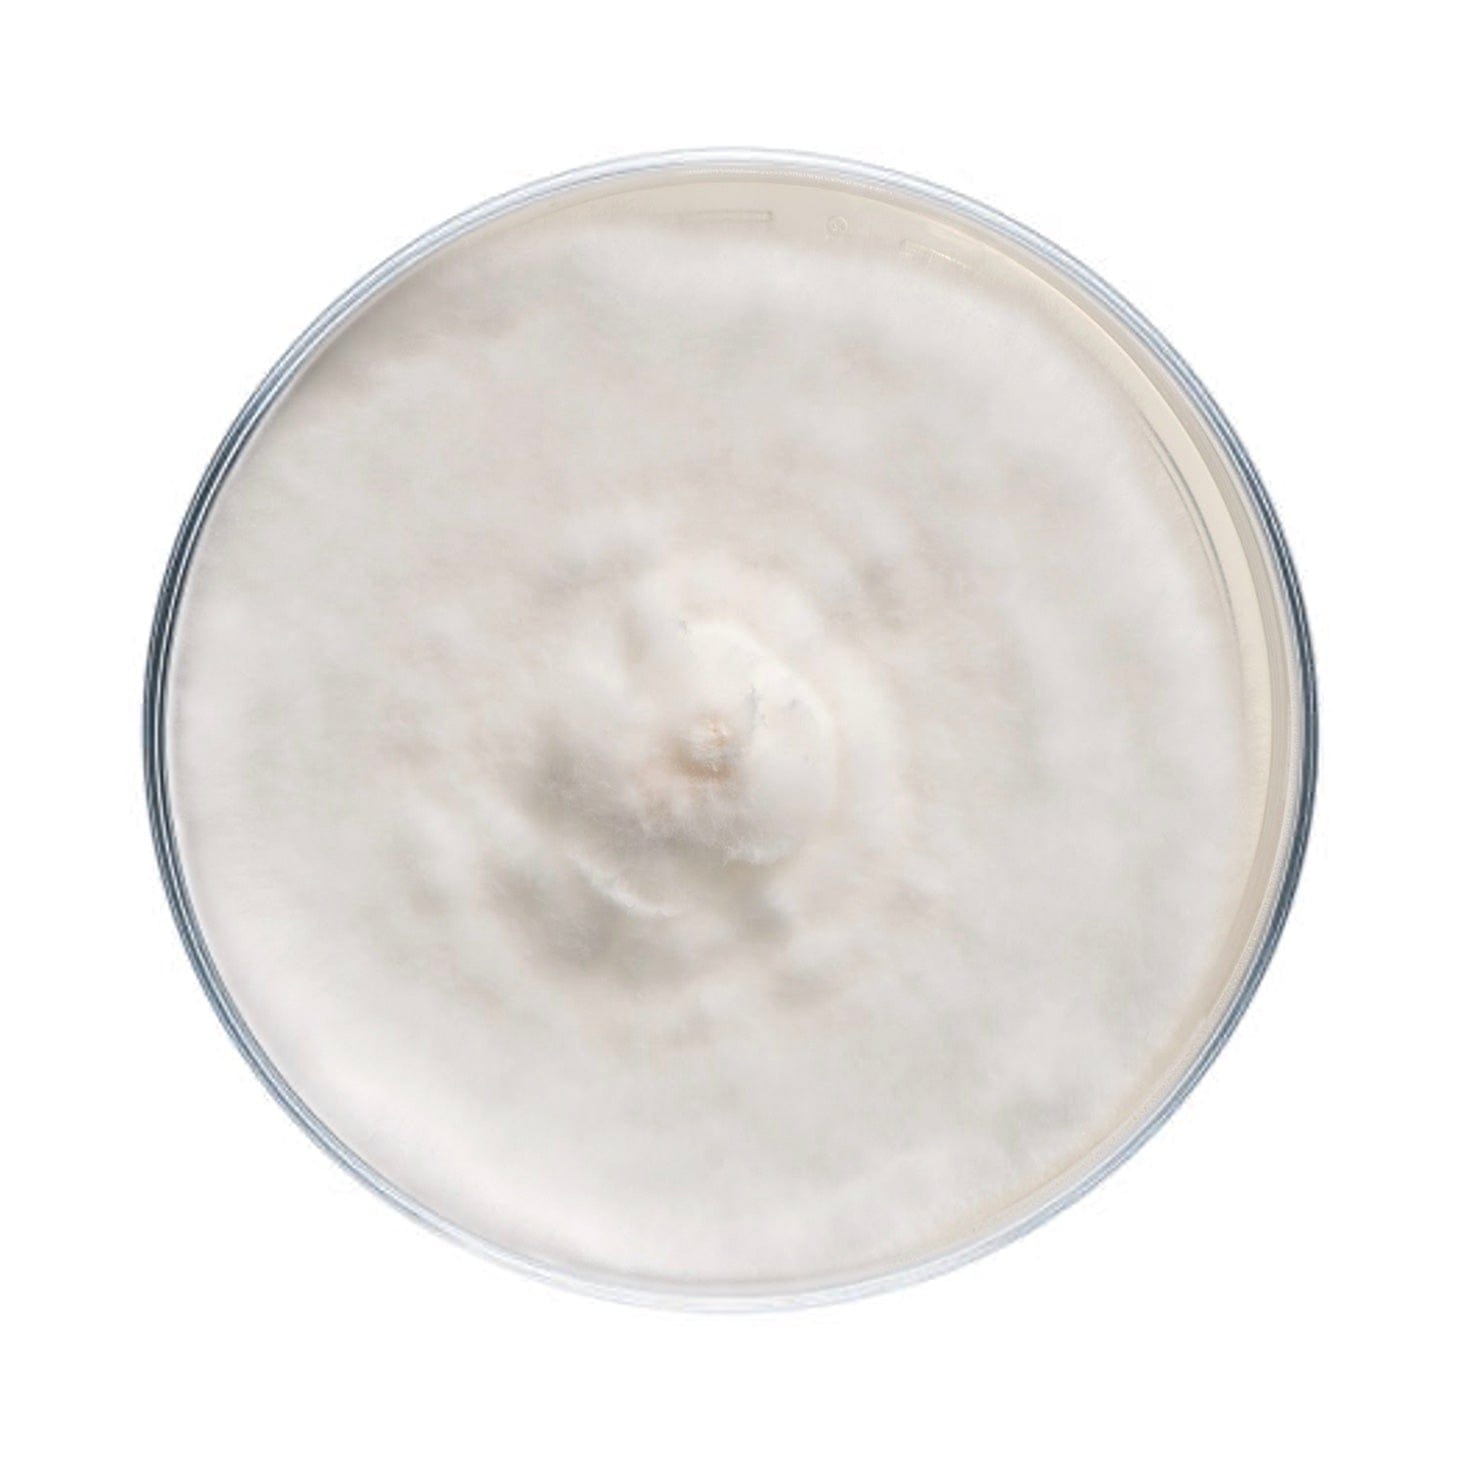
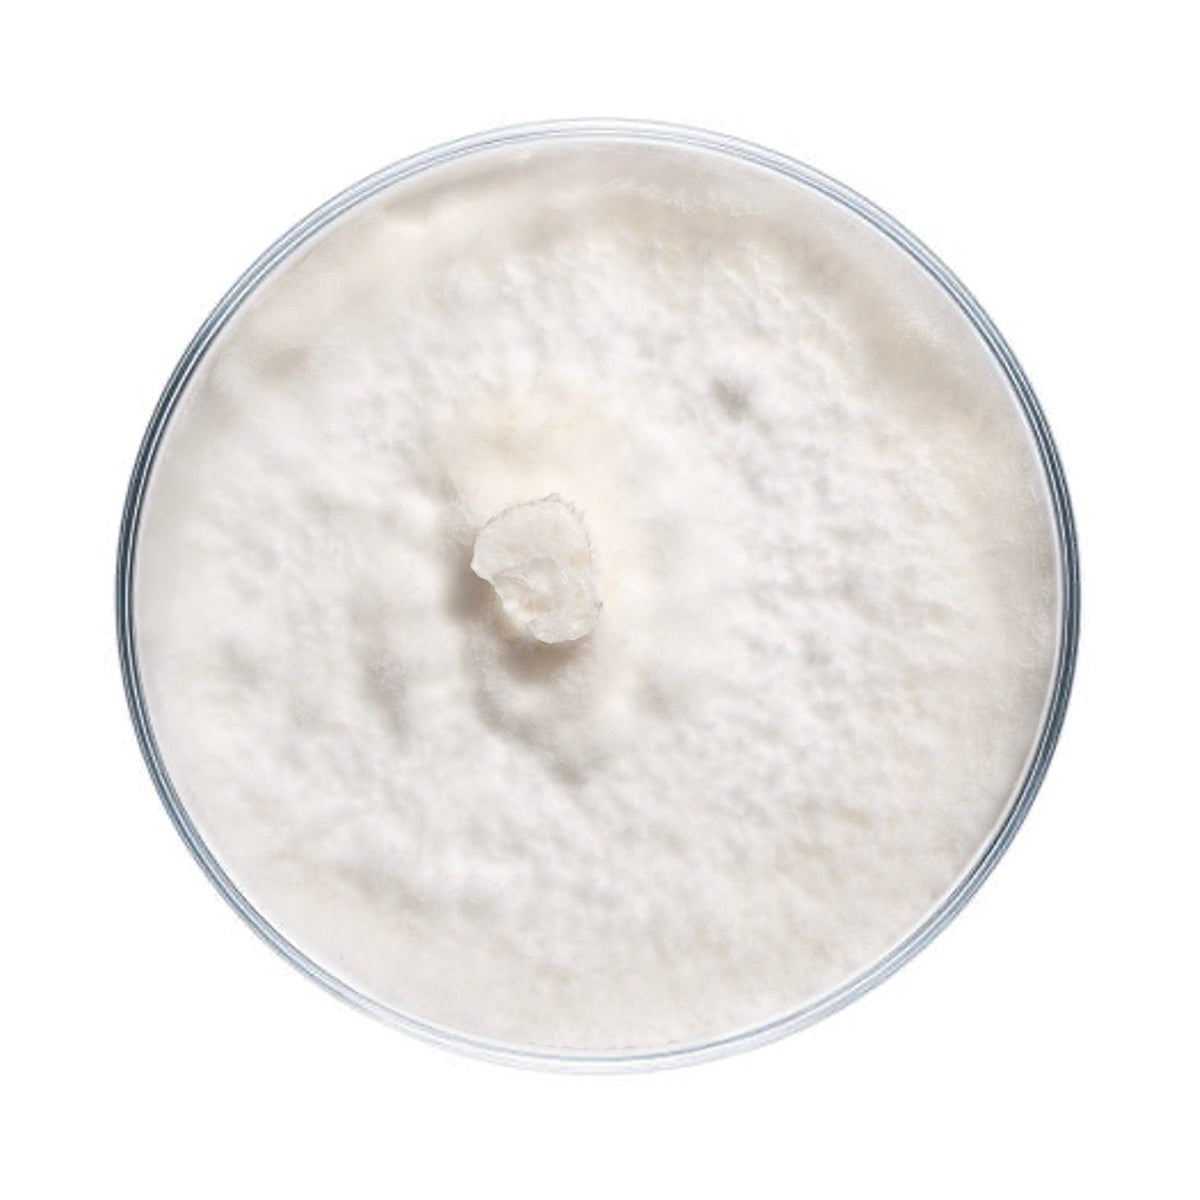
Culture Blue Oyster Mushroom Agar Plate Culture

Blue Oyster Mushroom Plate Culture
Culture plates are ideal for growers looking to make master bags, inoculate grain, make liquid culture, or make more plates.
Blue oyster culture plates are made to order and have a shelf life of approximately 6 months. They should be stored in the refrigerator to maintain viability. Note that mycelium cultures require basic lab skills. Handle using sterile technique to prevent contamination.
See full description of available blue oyster strains below.
NSPO1 - Harbor Blue Oyster
Pleurotus ostreatus. This is a very productive commercial strain of blue oyster from Pennsylvania. It produces dense clusters with dark gray/blue caps. It produces best in cooler temperatures but also performs well during the warmer months. Averages 1-2 lbs first flush off of 5 lb supplemented sawdust blocks but will also produce off sterilized straw substrate.
NSPO4 - Steely Blue Oyster
Pleurotus ostreatus. A steely blue oyster strain we prefer for outdoor spawn for log inoculations. Fruits best in cooler temperatures, up to 65 degrees.
NSPO5 - NV Blue Oyster
Pleurotus ostreatus. A blue oyster strain from Nevada. Unknown fruiting conditions.
NSPO8 - Quito Blue Oyster
Pleurotus ostreatus. A blue oyster culture from mushrooms cultivated in Quito, Ecuador.
NSPO9 - Bountiful Blue Oyster
Pleurotus ostreatus. A high-yielding blue oyster strain. Unknown source.
NSPO12 - Cap 'n Stem Blue Oyster
Pleurotus ostreatus. Developed by Erik Lomen at Cap N' Stem, a blue oyster strain featuring flushes of smaller caps.
NSPO15 - Shmoyster Blue Oyster
Pleurotus ostreatus. An alternative blue oyster strain. Darker and denser than our PO1 with a more impressive first flush but a lower tolerance for warm temperatures. A serious Oyster with a serious name.
NSPO16 - Big NV Blue Oyster
Pleurotus ostreatus. Big, beautiful blue oysters from Nevada with large fruiting bodies and a tolerance for higher CO2 levels.
NSPO17 - FL Blue Oyster
Pleurotus ostreatus. A slightly more delicate, hot weather loving blue oyster with shades of beige to pale gray-blue.
NSPO18 - CA Blue Oyster
Pleurotus ostreatus. Another good alternative to our PO1. Fast-growing. A very popular commercial blue oyster strain from California.
NSPO19 - King Blue Oyster
Pleurotus ostreatus. High-yielding, thick-stemmed "King Blue" oyster strain from Mossy Creek.
Frequently Asked Questions